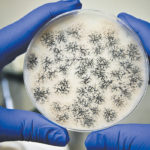

Proponents say developing an industry that processes plant proteins would help diversify the province’s economy
TABER, Alta. — Binders, emulsifiers, texturizers, foaming agents, gels: these are some of the uses for fractionated plant proteins. David Fielder, senior scientist and value-added fractionation program lead with Alberta Agriculture, said Alberta can be as competitive as other provinces in processing plant proteins for use in foods and other products. That would help diversify […] Read moreStories by Barb Glen

Study questions rest stop need
GATINEAU, Que. — Rest stops provided to calves amid 12-hour and 36-hour transport did not reduce fatigue, dehydration, stress or immune status, according to study results. Although two more years of study will provide more information on whether rest periods benefit cattle in transport, early results call into question the requirement for rest stops in […] Read more
New animal health group still a priority
GATINEAU, Que. — The spectre of African swine fever infecting pigs in Canada is giving more impetus to the potential formation of Animal Health Canada, an entity with the goal of improving animal disease prevention, preparedness, response and recovery. ASF’s continued spread in Asia and Eastern Europe is a concern because its arrival in Canada […] Read more
Varied livestock interests challenge development of new transport code
GATINEAU, Que. — The road is rocky for development of a new livestock transportation code of practice undertaken by the National Farm Animal Care Council. Unlike other codes that deal with one species and provide requirements and recommendations for care and handling, the transportation code involves 14 different species or livestock types and has no […] Read more

Grazing management pays off
Alberta cattle producer Sean McGrath has been employing intensive grazing methods for more than 20 years. Steve Kenyon has been doing it just about as long, and Alberta Agriculture grazing expert Grant Lastiwka has been studying it. All of which is to say that high-intensity grazing is sustainable. If you do it right. “From an […] Read more

Reduced antibiotic use remains on industry’s radar
Veterinarians say eliminating antibiotics in animal agriculture is not an option, but other options should also be considered
Antibiotics are vital to treat human and livestock illness and protect health. The development of bacteria resistant to antibiotics threatens the sustainability of their use in the medical and veterinary fields. Reducing the use of antibiotics, or antimicrobials in general, is a focus of widespread Canadian efforts in recent years. That reduction is expected to […] Read more
Susgrainable: baking with craft brewers’ leftovers
It seems like new craft breweries spring up every week across Western Canada. There are about 170 in British Columbia, 125 in Alberta, more than 20 in Saskatchewan and at least a dozen in Manitoba. Each markets its own tantalizing taste and attributes, but they all have one thing in common: spent grain that was […] Read more

Feds delay transport rule enforcement
Canada’s cattle and dairy sectors will have two years to familiarize themselves with the federal livestock transportation regulations that come into effect Feb. 20. Federal Agriculture Minister Marie-Claude Bibeau told cattle producers Dec. 11 that they’ll have a transition period before the Canadian Food Inspection Agency institutes hard enforcement that would include fines and penalties […] Read more
Alta. fires researchers to cut costs
The Alberta government Grinch stole Christmas from about 50 Alberta Agriculture employees last week. Managers and extension staff were either terminated or given terms of “working notice” in offices across the province as the government moved to cut costs in the department as it has or intends to do in most other sectors. “Alberta has […] Read more

Producers must know how to manage a crisis
A food safety or animal welfare problem can happen to anyone, but knowing what to do about it can make all the difference
GATINEAU, Que. — A third item can be added to the list of things that are inevitable. Besides death and taxes, farmers can be sure that at some point, things will go wrong. When they do, said issues management expert Geraldine Auston, “it’s what you do about it when things go wrong that matters.” Auston, […] Read more